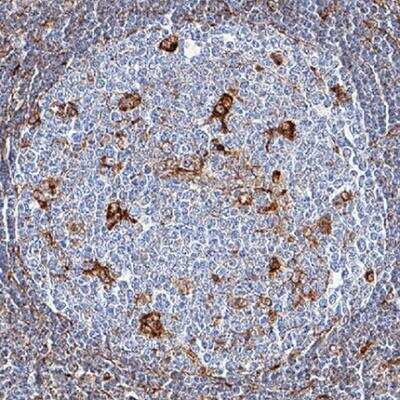

Vimentin Antibody (979542) [Unconjugated] - BSA Free
Novus Biologicals, part of Bio-Techne | Catalog # MAB21053


Conjugate
Catalog #
Key Product Details
Species Reactivity
Human
Applications
Immunohistochemistry, Immunohistochemistry-Paraffin, Western Blot, Immunocytochemistry/ Immunofluorescence
Label
Unconjugated
Antibody Source
Monoclonal Mouse IgG2B Clone # 979542
Format
BSA Free
Concentration
1.0 mg/ml
Product Specifications
Immunogen
E.coli-derived recombinant human Vimentin Antibody protein (amino acids 2-466)
Clonality
Monoclonal
Host
Mouse
Isotype
IgG2B
Theoretical MW
53.6 kDa.
Disclaimer note: The observed molecular weight of the protein may vary from the listed predicted molecular weight due to post translational modifications, post translation cleavages, relative charges, and other experimental factors.
Disclaimer note: The observed molecular weight of the protein may vary from the listed predicted molecular weight due to post translational modifications, post translation cleavages, relative charges, and other experimental factors.
Scientific Data Images for Vimentin Antibody (979542) [Unconjugated] - BSA Free
Immunocytochemistry/Immunofluorescence: Vimentin Antibody (979542) [Unconjugated] [MAB21053] - Vimentin was detected in immersion fixed HeLa human cervical epithelial carcinoma cell line using Mouse Anti-Human Vimentin Monoclonal Antibody (Catalog # MAB21053) at 8 ug/mL for 3 hours at room temperature. Cells were stained using the NorthernLights 557-conjugated Anti-Mouse IgG Secondary Antibody (red; Catalog # NL007) and counterstained with DAPI (blue). Specific staining was localized to cytoplasm (cytoskeleton).
Immunohistochemistry-Paraffin: Vimentin Antibody (979542) [Unconjugated] [MAB21053] - Vimentin was detected in immersion fixed paraffin-embedded sections of human lymph node tissue using Mouse Anti-Human Vimentin Monoclonal Antibody (Catalog # MAB21053) at 5 ug/mL for 1 hour at room temperature followed by incubation with the Anti-Mouse IgG VisUCyte HRP Polymer Antibody (Catalog # VC001). Before incubation with the primary antibody, tissue was subjected to heat-induced epitope retrieval using Antigen Retrieval Reagent-Basic (Catalog # CTS013). Tissue was stained using DAB (brown) and counterstained with hematoxylin (blue). Specific staining was localized to cytoplasm in lymphocytes in germinal centers.
Applications for Vimentin Antibody (979542) [Unconjugated] - BSA Free
Application
Recommended Usage
Immunocytochemistry/ Immunofluorescence
5 - 10 ug/ml
Immunohistochemistry
5 - 10 ug/ml
Immunohistochemistry-Paraffin
5 - 10 ug/ml
Western Blot
1:100 - 1:2000
Formulation, Preparation, and Storage
Purification
Protein A or G purified
Formulation
PBS
Format
BSA Free
Preservative
0.02% Sodium Azide
Concentration
1.0 mg/ml
Shipping
The product is shipped with polar packs. Upon receipt, store it immediately at the temperature recommended below.
Stability & Storage
Store at 4C short term. Aliquot and store at -20C long term. Avoid freeze-thaw cycles.
Background: Vimentin
Activated macrophages have been shown to secrete phosphorylated vimentin which can be stimulated by a variety of pathophysiological factors including oxidized low-density lipoproteins and TNF-alpha or inhibited by IL-10 (1). The vimentin protein is often expressed at the cell surface playing a role in cell-cell interactions, tissue damage and repair, immune response, and pathogen recognition (1). Vimentin functions in many cytoskeletal processes including cell migration, which is highlighted by its upregulation during epithelial-to-mesenchymal transition (EMT) (4,5). Vimentin is a commonly used marker for EMT and is expressed by many tumor types (5). For example, high metastasis of oral squamous cell carcinomas also showed high vimentin positive expression in immunohistochemical staining analysis (5). A number of vimentin targeting compounds are in cancer-related clinical trials, however, given the multifunctional role of vimentin, the effect of inhibition on non-malignant cells needs to be thoroughly examined (5).
References
1. Ramos, I., Stamatakis, K., Oeste, C. L., & Perez-Sala, D. (2020). Vimentin as a Multifaceted Player and Potential Therapeutic Target in Viral Infections. International Journal of Molecular Sciences. https://doi.org/10.3390/ijms21134675
2. Uniprot (P08670)
3. Morrow, C. S., & Moore, D. L. (2020). Vimentin's side gig: Regulating cellular proteostasis in mammalian systems. Cytoskeleton (Hoboken, N.J.). https://doi.org/10.1002/cm.21645
4. van Bodegraven, E. J., & Etienne-Manneville, S. (2020). Intermediate filaments against actomyosin: the david and goliath of cell migration. Current Opinion in Cell Biology. https://doi.org/10.1016/j.ceb.2020.05.006
5. Strouhalova, K., Prechova, M., Gandalovicova, A., Brabek, J., Gregor, M., & Rosel, D. (2020). Vimentin Intermediate Filaments as Potential Target for Cancer Treatment. Cancers. https://doi.org/10.3390/cancers12010184
Alternate Names
VIM
Gene Symbol
VIM
Additional Vimentin Products
Product Documents for Vimentin Antibody (979542) [Unconjugated] - BSA Free
Product Specific Notices for Vimentin Antibody (979542) [Unconjugated] - BSA Free
This product is for research use only and is not approved for use in humans or in clinical diagnosis. Primary Antibodies are guaranteed for 1 year from date of receipt.
Loading...
Loading...
Loading...
Loading...